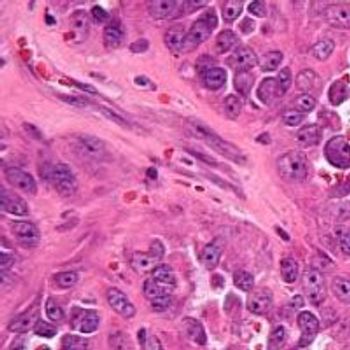

A marketing authorization application has been submitted to the European Medicines Agency for the approval of the CAR T-cell therapy ciltacabtagene autoleucel in the treatment of patients with relapsed and/or refractory multiple myeloma.

A marketing authorization application has been submitted to the European Medicines Agency for the approval of the CAR T-cell therapy ciltacabtagene autoleucel in the treatment of patients with relapsed and/or refractory multiple myeloma.

Daratumumab appears to be safe when used as consolidation therapy in patients with multiple myeloma, even soon after autologous stem cell transplant, and the agent has also demonstrated early efficacy in the setting of very good responders.

The rolling submission of a biologics license application to support the approval of the investigational BCMA-directed CAR T-cell therapy ciltacabtagene autoleucel for the treatment of patients with relapsed/refractory multiple myeloma has been completed.

The multitumor-associated antigen-specific T-cell product MT-401 is under investigation as a potential treatment option for patients with acute myeloid leukemia following allogeneic stem cell transplant in both the adjuvant and active disease settings.

Axicabtagene ciloleucel elicited a high objective response rate of 85%, with a complete response rate of 74% when used as a first-line therapy in patients with high-risk large B-cell lymphoma.

February 24, 2021 - The CAR T-cell product KTE-X19 continues to demonstrate durable clinical benefit in patients with relapsed/refractory mantle cell lymphoma, with an overall response rate of 92%.

Treatment with the investigative gene cell therapy betibeglogene autotemcel led to durable transfusion independence in 87% of pediatric patients less than 18 years of age with transfusion-dependent beta-thalassemia with a median average hemoglobin of 11.3 g/dL.

Prior exposure to anti-CD19 therapy did not impact response to the CAR T-cell therapy lisocabtagene maraleucel in patients with relapsed/refractory large B-cell lymphoma.

February 5, 2021 - Following stem cell transplant or treatment with CAR T-cell therapies, patients with hematologic malignancies and coronavirus disease 2019 tend to have favorable outcomes, especially if they are diagnosed in complete remission and further out from their cell infusion.

January 22, 2021 — The Japan Ministry of Health, Labour and Welfare has approved the CAR T-cell therapy axicabtagene ciloleucel for use in the treatment of adult patients with certain relapsed/refractory large B-cell lymphomas.

January 4, 2021 - The biologics license application for the CAR T-cell product lisocabtagene maraleucel in adult patients with relapsed/refractory large B-cell lymphoma following at least 2 previous therapies continues to be under regulatory review by the FDA, and a decision on the application has not yet been reached.

December 30, 2020 - Bristol Myers Squibb has withdrawn nivolumab from the US market for the treatment of patients with small cell lung cancer who have experienced disease progression after a platinum-based chemotherapy and at least 1 other line of therapy.

December 21, 2020 - A rolling submission of the biologics license application for the BCMA-directed CAR T-cell product ciltacabtagene autoleucel for use in adults with relapsed/refractory multiple myeloma has been initiated to the FDA.

December 17, 2020 — The European Commission has granted a conditional marketing authorization to the CD19-targeted CAR T-cell therapy KTE-X19 for use in adult patients with relapsed or refractory mantle cell lymphoma who had previously received 2 or more lines of systemic therapy including a BTK inhibitor.

Treatment with the BCMA-targeted CAR T-cell therapy idecabtagene vicleucel was found to yield clinically meaningful improvements in the quality-of-life of triple-class exposed patients with relapsed/refractory multiple myeloma.

December 3, 2020 — The survivin-targeted T-cell therapy DPX-Survivac, when used in combination with intermittent low-dose cyclophosphamide, prolonged clinical benefit with promising tolerability in patients with recurrent, advanced platinum-sensitive and -resistant ovarian cancer.

December 2, 2020 - Patients with high-grade Bacillus Calmette-Guérin unresponsive non-muscle invasive bladder cancer who responded to the investigational gene therapy nadofaragene firadenovec had a lower rate of cystectomy and delayed time to cystectomy compared with those who did not respond.

November 18, 2020 - The FDA has decided to lift the clinical hold placed on the phase 1 MELANI-01 trial, which is examining the CAR T-cell therapy UCARTCS1 as a treatment for patients with relapsed/refractory multiple myeloma.

November 17, 2020 - The review of the biologics license application for the CAR T-cell product lisocabtagene maraleucel for the treatment of adult patients with relapsed/refractory large B-cell lymphoma following at least 2 previous therapies has been delayed.

The combination of lenvatinib plus pembrolizumab demonstrated encouraging antitumor activity in patients with metastatic clear cell renal cell carcinoma who had progressed on prior PD-1 or PD-L1 immune checkpoint inhibitor therapy.

The FDA has lifted the clinical hold placed on the phase 1 PSMA-101-001 study of the CAR T-cell therapy P-PSMA-101 in patients with metastatic castration-resistant prostate cancer.

The European Medicines Agency’s Committee for Medicinal Products for Human Use has adopted a positive opinion for KTE-X19 as a treatment in adult patients with relapsed/refractory mantle cell lymphoma who previously received 2 or more lines of systemic therapy, including a BTK inhibitor.

The investigational advanced cell therapy omidubicel resulted in rapid platelet engraftment and reduced the number of infections and hospitalizations in patients with high-risk hematologic malignancies, meeting all 3 secondary end points of a phase 3 trial.

The FDA has granted a breakthrough therapy designation to IMGN632 for the treatment of patients with relapsed or refractory blastic plasmacytoid dendritic cell neoplasm.

Blinatumomab monotherapy as consolidation therapy prior to allogeneic hematopoietic stem cell transplant resulted a significant improvement in event-free survival and a lower risk of recurrence in children with high-risk B-cell precursor–acute lymphoblastic leukemia.

The FDA has placed a clinical hold on the phase 1 P-PSMA-101-001 trial examining the autologous CAR T-cell therapy P-PSMA-101 in patients with metastatic castration-resistant prostate cancer.

Debio 1143 in combination with standard cisplatin-based concomitant fractionation chemoradiation therapy was found to induce a statistically and clinically significant improvement in overall survival compared with CRT alone in patients with high-risk locally advanced squamous cell carcinoma of the head and neck.

A CD30-targeted CAR T-cell therapy was found to elicit a high rate of durable complete responses (CRs) in heavily pretreated patients with relapsed/refractory Hodgkin lymphoma.

The FDA has granted a breakthrough therapy designation to MK-6482 for the treatment of patients with von Hippel-Lindau disease–associated renal cell carcinoma who have nonmetastatic tumors of less than 3 centimeters, unless immediate surgery is necessitated.
The European Medicines Agency has granted access to the PRIME initiative for the Specific Peptide Enhanced Affinity Receptor T-cell therapy ADP-A2M4 for the treatment of patients with synovial sarcoma.